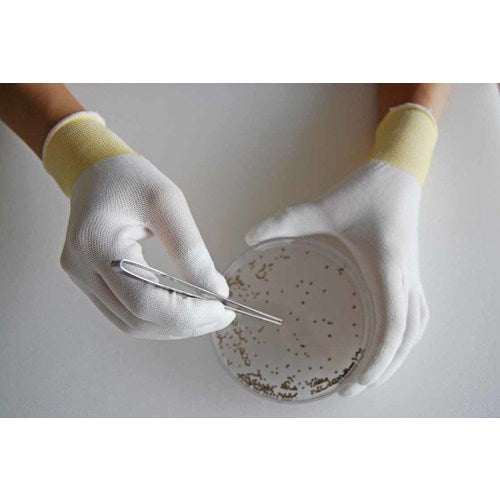

1
/
of
11
ショーワグローブ(株)
SHOWA bulk purchase simple packaging Top Fit gloves 10 pairs B0601 White L size B0601-L10P 1 bag
SHOWA bulk purchase simple packaging Top Fit gloves 10 pairs B0601 White L size B0601-L10P 1 bag
Regular price
¥2,348
Regular price
Sale price
¥2,348
Unit price
/
per
Shipping calculated at checkout.
Couldn't load pickup availability
Catalog number: B0601-L10P Features: ●The fingertips are coated with urethane foam resin, providing high anti-slip effect and excellent breathability. ●These gloves use long fibers, making them low-dust and less likely to generate dust or lint. ●They are less likely to become stuffy, so they can be used as an alternative to finger cots. ●They are a simple packaging type with excellent cost performance. ●We have reduced packaging materials to be environmentally friendly. Applications: ●Assembly and inspection of parts. ●Precision machinery industry. Specifications: ●Color: White ●Size: L ●Total length (cm): 20.0 ●Palm circumference (cm): 18.5 ●Middle finger length (cm): 7.5 ●Thickness (mm): Approximately 0.6 ●Gauge number: 13 ●Wrist color: Gold ●13 gauge knitting ●For both left and right hands ●Simple packaging Material/Finish: ●Fiber part: Nylon, polyester, etc. ●Anti-slip part: Polyurethane (PUR) Caution: ●This is not a clean pack.
View full details